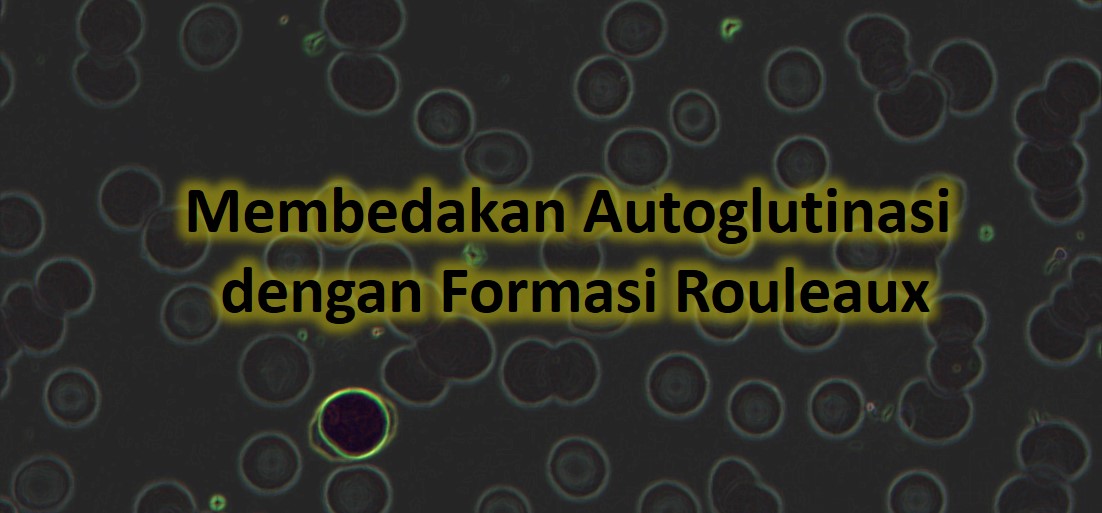
Membedakan Autoglutinasi dengan Formasi Rouleaux
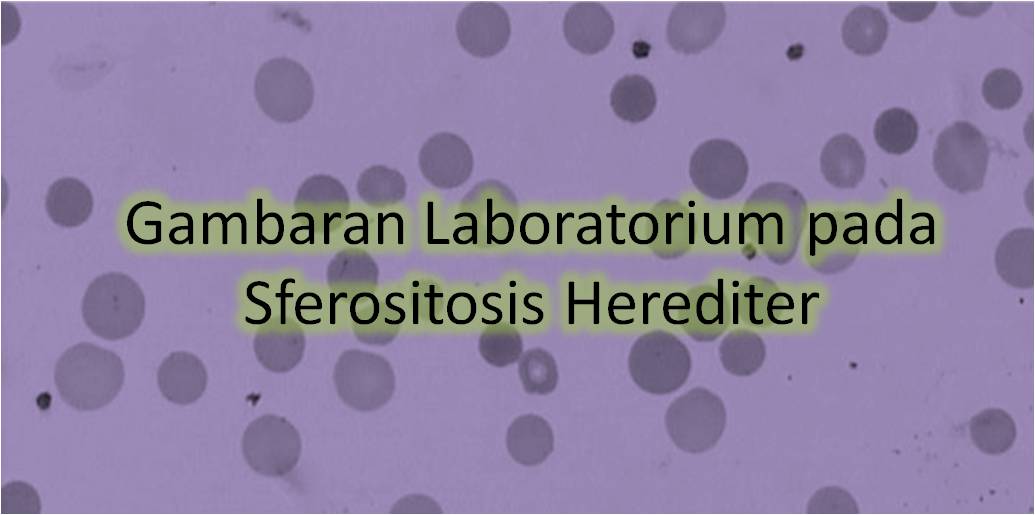
Gambaran Laboratorium pada Sferositosis Herediter

Metode Pemeriksaan Badan Inklusi HbH (Gambaran Bola Golf)
Badan inklusi eritrosit yang dianggap paling penting ada tiga, yaitu badan inklusi HbH pada thalassemia α, Heinz bodies pada penyakit haemoglobin tidak stabil (contoh pada defisiensi G6PD), dan badan inklusi rantai α pada thalassemia β mayor. Gambaran inklusi HbH pada eritrosit tampak setelah dilakukan pengecatan brilliant cresyl blue (BCB) dengan








![[Download] Hemoglobinopathies: Current Practices for Screening, Confrmation and Follow-up](/content/images/uploads/2019/05/Picture1-1-e1558751159471.jpg)